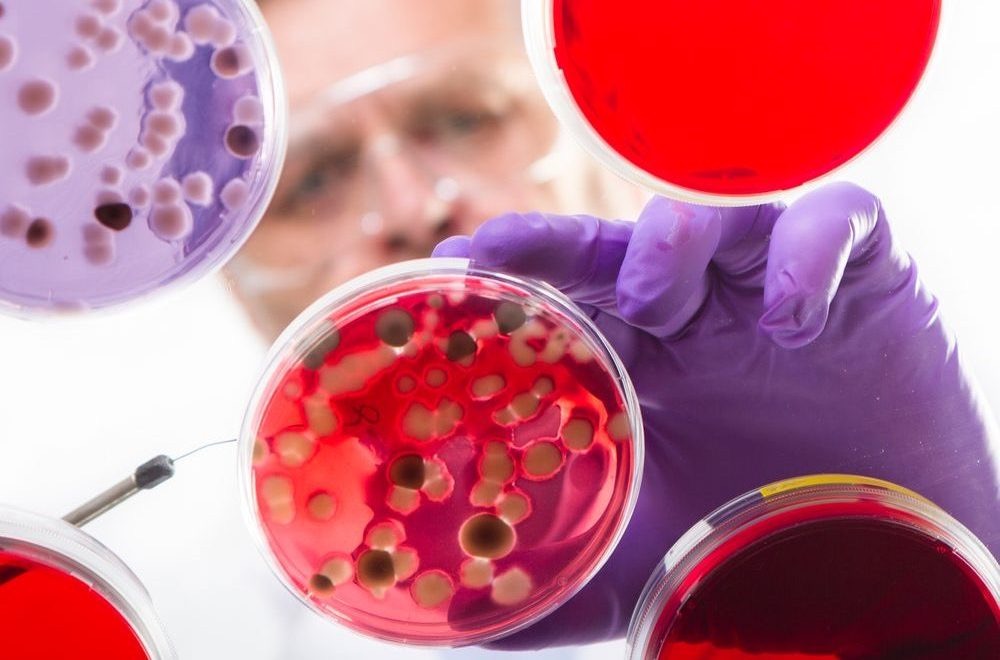

ВСЯ ПРАВДА О...стволовые клетки
Алёна ВОЙС 

Hey guys, что за тема вообще?
Многие клетки нашего тела живут меньше, чем мы. Кожа постоянно обновляется, бурлит жизнь в кишечнике, мы теряем и вырабатываем новую кровь… Стволовые клетки (СК) сидят до поры до времени в специальных нишах и ждут звёздного часа: когда поступит сигнал, что нужно делиться. Нет, не нажитым имуществом, а плодиться и размножаться. Вот тогда они оперативно создают для нас новые клетки – крепкие и здоровые.
Кстати, «стволовые клетки» – термин удобный, но не точный. На самом деле есть несколько разновидностей клеток: эмбриональные (образуются на ранних стадиях развития эмбриона, буквально на пятый день его жизни), фетальные (образуются на 9-12-й неделе беременности), постнатальные (клетки взрослого организма, их в свою очередь тоже несколько видов). Каждый вид имеет собственные «суперспособности» и ограничения, изучается отдельно и вызывает разные вопросы юридического и этического характера.
И как давно это у вас?
Термин «стволовые клетки» предложил российский учёный Александр Максимов в 1908 году. В моду и под свет рампы наши героини вышли относительно недавно, но используются довольно давно: с 70-х годов прошлого века людям, больным лейкозом, пересаживают донорский костный мозг, чтобы заново запустить кроветворение после гибели от химиотерапии собственных кровяных клеток. А это по факту донорство стволовых клеток.
Оно вам надо?
Теоретически (а местами и в лабораториях – практически) с помощью СК можно лечить:
- онкологические заболевания
- сердечно-сосудистые заболевания
- неврологические (такие как Альцгеймер и Паркинсон, рассеянный склероз)
- сахарный диабет 2-го типа
- заболевания опорно-двигательного аппарата (особенно суставов).
На территории нашей страны, где пока не могут договориться о юридических аспектах СК, всё же официально признаётся эффективность лечения донорскими СК таких заболеваний, как алопеция, атрофические поражения кожи, ожоги, цирроз печени, гепатиты, острые нарушения кровоснабжения нижних конечностей и др.
Из стволовых клеток можно создать любой орган и ткань.
(Миф... и правда)
Видов СК много – и каждый предназначен для того, чтобы создавать определенный орган или ткань. СК мозга не могут создать сердечную мышцу. Более того, есть несколько видов клеток крови, и для каждой свои СК.
Есть, правда, исключение, породившее миф: эмбриональные СК действительно способны при определённых условиях превращаться в разные виды взрослых клеток, но эта способность пока мало изучена и сопряжена с вопросами этики.
К счастью, Шиня Яманака, профессор Института передовых медицинских наук Университета Киото, придумал (вот ведь молодец!), как взрослые клетки превращать в эмбриональные стволовые с помощью методов генной инженерии, за что и получил Нобелевку в 2006 году. Такие модифицированные клетки он назвал красиво и длинно: индуцированные плюрипотентные (многофункциональные) СК. Метод потрясающ тем, что не только поможет в перспективе лечить серьёзные болезни, но и снимает вопросы этики и совместимости клеток.
Пуповинная кровь, в которой много стволовых клеток, лечит от всего.
(Миф)
70-80 мл взятой вовремя и сохраненной правильно пуповинной крови способны восстановить кроветворение человека весом до 50 кг. Чувствуете подвох? Только кроветворение. И только у ребёнка или подростка (большинство из нас весят всё же больше 50 кг). Так что заморозка пуповинной крови – это «каско» нашего организма. А ещё шанс спасти жизнь чужому человеку (одному из 10000).
Стволовые клетки станут персональным лекарством – без побочных эффектов.
(Правда)
Многие лекарства даже не выходят на рынок, потому что имеют побочные эффекты, например, токсичны для печени. Эксперименты с СК помогут определить, насколько лекарство опасно в целом – и для конкретного человека, который в нём нуждается.
Кроме того, уже сейчас во всём мире проводятся эксперименты, суть которых в следующем: у больного забирают повреждённые клетки, делают их стволовыми плюрипотентными (помните такие?), затем снова повреждают до болезненного состояния. Но теперь у учёных больше экспериментального материала, чтобы проверить гипотезы лечения и эффективность лекарств.
Есть и другой вариант: больную клетку преобразовывают в стволовую, затем – в здоровую и подсаживают обратно в организм, позволяя там делиться. Тем самым (сильно упрощаем) болезнь отступает из-за преобладания здоровых клеток над больными. Всё тот же нобелевский лауреат Яманака (миллион плюсиков ему к карме!) уже лечит заболевание глаз макулодистрофию таким способом.

Уколы со стволовыми клетками – путь к раку.
(Миф. А может, правда)
Начнем с того, что СК в кожу шприцами не вводят. А то, что вводят, – это не СК (как бы громко их в соответствующих косметологических учреждениях ни называли). Это могут быть фибробласты (клетки кожи клиента), растительные СК (мы о них ещё расскажем). Что до экспериментального лечения СК – то вопрос пока недостаточно изучен. Так, учёные из Мадридского университета объявили на весь мир, что имплантация размноженных в пробирке СК вызывает рак. Так что прибегают исследователи к такому лечению только в действительно крайних случаях.
Косметические средства со стволовыми клетками возвращают молодость.
(Миф. И полуправда)
Речь тут о растительных СК (корректнее называть их меристемными). Согласно утверждениям производителей таких средств (сюрприз!), так называемые фитостволовые клетки действительно помогают коже сохранить упругость, заставляя активнее работать собственные клетки кожи человека – фибробласты. Но даже здесь есть нюанс: целиком в организм человека такие клетки не попадают, а только полезными частями – пептидными или ферментными комплексами. Частью человеческого организма фито-СК (фитоэкстракты) не становятся, а лишь помогают защитить кожу от вредного воздействия окружающей среды. Баталии вокруг фито-СК развернулись нешуточные. Одни заинтересованные лица приводят в пример чудо-регенерацию, свойственную растениям. Другие напоминают, что СК растений и животных (в том числе человека) отличаются, взаимодействовать не могут; что ни в одном креме живая клетка не выживет, а если выживет – едва ли роговой слой кожи пропустит её к слоям, отвечающим за молодость и упругость; наконец, что в составе любого крема столько чудо-компонентов, что невозможно определить влияние какого-то одного. В общем, экспериментируйте! Эффект плацебо ещё никто не отменял.
Научные исследования СК только начинаются. Понадобятся годы исследований и экспериментов для появления и повсеместного использования методов клеточного лечения, омоложения или косметики на основе СК.
В общем, ждём-с.
P.S. А пока не ведитесь на маркетинговые уловки и аргументы шарлатанов ;)

г. Чебоксары +7 (8352) 211-711
twitter @kitmediagroup
vkontakte @journal_ikra
instagram @journal_ikra